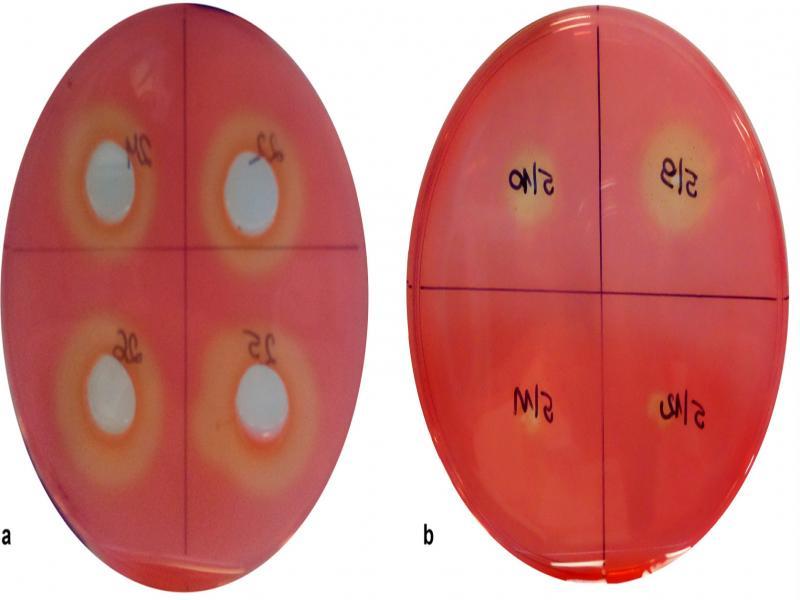

Cellulose is the most abundant organic material in the biosphere and dominating waste in agriculture (Shrestra et al. 2017). One of the agriculture by-products with a large cellulose content is cereal straws. Wheat, rye, barley, oats, and oilseed rape are the most popular straws in Poland. Some of them can be collected and used for various applications as bedding or compost production or a food supplement. However, much simpler for farmers and much better for soil is to leave the straw residues to increase the content of available nutrients and humus in the soil. Microorganisms play the important role in cellulose degrading in the natural environment. They evolved different mechanisms to degrade cellulose, lignocellulose, and hemicelluloses, mostly based on producing and secreting a combination of synergistically active enzymes (hydrolytic glycoside hydrolases, carbohydrate esterases, polysaccharide lyases and cellodextrin phosphorylases) (Bomble et al. 2017). Microorganisms with such activity often occur in niches rich in cellulose. Generally, that microorganisms isolated from the natural environment have better activity than these from laboratory collections and may be used as a component of biopreparations (Pietraszek and Walczak 2014).
Nowadays agriculture is based on the economy, process efficiency, and ecology. The balance between those factors is possible only in the case of simultaneously increasing of the crops productivity and decrease of costs. One of the most important issues in ecological agriculture is the use of microbial biopreparations for the crop production instead of chemicals. These biopreparations may contain microorganisms (bacteria or fungi) with valuable properties, such as the ability to synthesize enzymes (e.g. cellulases), fix molecular nitrogen, and also to be active against plant pathogens, etc. (Kyrychenko 2015). Their roles consist of restoration of soil fertility, ensuring of plants in biologically active substances (e.g. hormones or vitamins), improvement of nitrogen and phosphorus nutrition of plants, and biological protection against pathogenic organisms.
The aim of this study was to isolate from the environmental samples the microorganisms with high cellulolytic activity, which are able to grow and synthesize of the enzyme in a wide spectrum of temperature from cheap nitrogen source and may be used as a component of biopreparations.
Strains isolation. The strains were obtained from the sources rich in cellulose like wheat straw, compost, soil, etc. Overall, 72 strains were isolated from straw (one sample), 22 from compost (one sample) and 120 strains from soil reach in postharvest leftovers (six samples). Samples were collected in sterile plastic jars and stored in the refrigerator until experimentations. The strains were isolated using serial dilutions and pour plate technique. The sample suspensions were cultured on medium I (according to Gupta et al. 2012) containing (in g/l) casein peptone 10.0; carboxy-methyl cellulose-Na (CMC-Na) 10.0; (NH4)2SO4 2,5; K2HPO4 2.0; gelatin 2.0; MgSO4 ∙ 7H2O 0.3; agar 15.0; pH 6.9–7.1, and incubated at 32°C for 72 h. Subsequently, single colonies were picked and spread onto modified medium II (according to Liang at al. 2014) consisted of (g/l): K2HPO4 1.5; (NH4)2SO4 1.5; MgSO4∙7H2O 0.3; Na2HPO4 ∙ 7H2O 2.5; MnSO4 0.0016; agar 15; pH 7.0. The plates were incubated for 48 h, at 32°C. After incubation, the pure cultures were transferred to nutrient broth (in g/l: peptone 15.0; glucose 10.0) and preserved at 4°C for further screening. Two strains of Bacillus spp. (26b – Bacillus circulans, 29b – Bacillus coagulans) from the collection of the Department of Biotechnology and Food Microbiology were also used as reference samples.
Screening of cellulose-degrading bacteria. The strains isolated were pre-cultured overnight in nutrient broth at 32°C. Subsequently, 0.2 ml of the culture was inoculated into 20 ml test-tube containing 10 ml of the medium I (without agar and gelatin – liquid medium), incubated at 32°C for 48 h with shaking (160 rpm). After incubation, the cultures were centrifuged at 4500 rpm for 10 min. The supernatant and biomass were collected for further experiments. The ability of isolated strains to degrade cellulose was investigated using a diffusion method (Mayrhofer et al. 2008; Pastuszewska and Gryń 2013). Biomass was inoculated directly on the medium I (as a spot). Additionally, for the cell-free supernatant control, a sterile cork borer (12 mm of diameter) was used to cut uniform wells. Each well was filled with 250 µl of the supernatant obtained from the selected isolates. After incubation, the plates were stained with 1% Congo red solution for 15 min, discolored with 1 M NaCl for 15 min, and the clearance zones were observed (Kasana et al. 2008) – Fig. 1.
CMC agar plate after staining with Congo red and NaCl.
(a) determination of the supernatant activity; (b) determination of the biomass activity.
Cell morphology of isolated microorganisms was determined using a Gram-staining method and observation under a light microscope (Zeiss Primo Star, magnitude 1000 ×). The Schaeffer-Fulton staining method was used for evaluation of the spore formation ability by the bacteria examined.
Identification of bacterial species. Total DNA from the bacteria was extracted using Genome Mini AX Bacteria Kit (A&A Biotechnology, Gdańsk, Poland) after initial incubation in 50 mg/ml lysozyme (Sigma) for 1 h at 37°C. Sequences encoding a small subunit of rRNA were amplified in PCR reaction using primers SDBact0008aS20 and SUniv1492bA21 (Suau et al. 1999). PCR products were purified using Clean-up Kit (A&A Biotechnology, Gdańsk, Poland) and sequenced at the Genomed, Warsaw, Poland with primers used for PCR and additionally for the inner sequence with the primer of the following sequence: GTGCCAGC-MGCCGCCCTAA. The sequences obtained were then arranged into contigs and identified in BLAST services of the GenBank database (Altschul et al. 1990).
Enzyme assay. The cellulose-degrading enzyme’s activity was measured by the amount of reducing sugar using the 3,5-dinitrosalisic acid (DNS) (Miller 1959). The selected isolates were grown in the medium I at 32°C. Enzyme production during fermentation was tested at 24 h intervals for four days. The culture broth was subjected to centrifugation at 4500 rpm for 10 min at 4°C. The supernatant was collected and used as a crude enzyme for further study. In this study, three types of cellulose substrates were used: CMC-Na (Sigma), filter paper (Whatman no 1) and wheat straw (milled straw, Retsh SM 100). The supernatant (1.0 ml) was added to: 0.5 ml of 1% CMC-Na in 0.05 M phosphate buffer (Irfan et al. 2012), 0.5 ml of 0.05 M sodium citrate buffer containing Whatman no. 1 filter paper strip (1 cm × 1 cm) (Gupta et al. 2012) and 0.5 ml of 0.05 M sodium citrate buffer containing chopped straw (0.05 g). The mixtures were incubated for 1 h at 30°C. The reaction was stopped by adding 1.5 ml of DNS reagent and the samples were heated for 5 min in boiling water. The amount of reducing sugar was determined by measuring absorbance at 540 nm. In these tests, the enzyme production was estimated using glucose standard and was defined in units (U). One unit (U) of enzyme activity was expressed as the amount of enzyme, which released 1µmol of reducing sugars equivalent to glucose per ml per minute (Adney and Baker 1996).
Optimization of biosynthesis of cellulose-degrading enzymes. Temperature. The selected isolates colonies were inoculated in 300 ml Erlenmeyer flask containing 150 ml medium I and incubated under the shaking (100 rpm) for 48 h at different temperatures: 4, 15, 21, 27, 32, 37, and 42°C. After incubation, 10 ml of culture was centrifuged (10 min, 4500 rpm) and 1 ml of supernatant was used for the measurement of reducing sugars (Enzyme Assay).
Nitrogen source. All experiments were carried out in 300 ml flasks containing 150 ml of the basic medium, inoculated with 2% inoculum and then incubated at 32°C for 120 h. The basic culture medium was composed of 10 g/l of various carbon source (CMC-Na, filter paper, and milled wheat straw), 2.0 g/l K2HPO4, 2.5 g/l MgSO4 ∙ 7H2O, and the initial pH was 7.0. The preparation of basic culture medium containing various nitrogen sources was carried out considering the fractions of substitution determined by the mixture design. D-optimal mixture design was adopted to study the relationship between the proportion of the four different nitrogen sources (casein peptone, ammonium sulfate, yeast extract, and ammonium chloride) and activity of cellulose-degrading enzymes. A characteristic feature of the experimental design of the mixtures is the condition of factor summability and linear restrictions on the values of these factors. In practice, it means that in an assumed experimental variant, the individual factor levels were fractions, which sum was always equal to 1 (Bialas at al. 2016). The following vertexes were adopted in the experimental design: permutations of blends containing only one compound, permutations of blends containing two compounds at equal quantities, permutations of blends containing three compounds, and permutations of blends containing four compounds at equal as well as different quantities (Table I). The design was implemented using Design Expert 11.0 software (Stat-Ease Inc., USA) and the proportion of each nitrogen source varied from 0 to 1 (0 to 5 g/l). The center point and check blends were added to the design. The order in which the experiments were performed was randomized, which fulfills the requirement for independent and random distribution of observations. Such practice helps avoid the influence of unknown nuisance variables.
Composition of the nitrogen sources blends according to the mixture design.
| Run | A: Casein peptone (g/l) | B: (NH4)2SO4(g/l) | C: Yeast extract (g/l) | D: NH4Cl (g/l) |
|---|---|---|---|---|
| 1 | 5.00 | 0.000 | 0.000 | 0.000 |
| 2 | 0.00 | 5.000 | 0.000 | 0.000 |
| 3 | 0.00 | 0.000 | 5.000 | 0.000 |
| 4 | 0.00 | 0.000 | 0.000 | 5.000 |
| 5 | 1.25 | 1.250 | 1.250 | 1.250 |
| 6 | 3.13 | 0.625 | 0.625 | 0.625 |
| 7 | 0.63 | 3.125 | 0.625 | 0.625 |
| 8 | 0.63 | 0.625 | 3.125 | 0.625 |
| 9 | 0.63 | 0.625 | 0.625 | 3.125 |
| 10 | 2.50 | 0.000 | 0.000 | 2.500 |
| 11 | 2.50 | 0.000 | 2.500 | 0.000 |
| 12 | 2.50 | 2.500 | 0.000 | 0.000 |
| 13 | 0.00 | 2.500 | 0.000 | 2.500 |
| 14 | 0.00 | 2.500 | 2.500 | 0.000 |
| 15 | 0.00 | 0.000 | 2.500 | 2.500 |
| 16 | 2.50 | 0.000 | 2.500 | 0.000 |
| 17 | 5.00 | 0.000 | 0.000 | 0.000 |
| 18 | 0.00 | 5.000 | 0.000 | 0.000 |
| 19 | 0.00 | 0.000 | 5.000 | 0.000 |
| 20 | 0.00 | 0.000 | 0.000 | 5.000 |
The statistical analysis of the experimental mixture design was performed by backward stepwise regression. The model was simplified to exclude terms that were not considered statistically significant (p < 0.05) by analysis of variance (ANOVA). The accuracy and general ability of the mathematical model were evaluated using the adjusted coefficient of determination Adj-R2 and model p-value. The final goal of this part of the study was to find an optimal mixture composition, which maximizes enzyme activity. To solve the optimization problem, the desirability function approach developed by Deringer and Suich (1980) was applied. Before optimization, the predicted values of dependent variables in different combinations of levels of the predictor variables were transformed into individual desirability scores and then the overall desirability of the outcomes at different combinations of levels of the predictor variables was computed. To determine the optimal mixture composition, maximization of the overall desirability function was performed. If the response variable was at its goal or target, then D = 1, and if the response variable was outside of an acceptable region, then D = 0.
Isolation, screening, and identification of cellulose-degrading microorganisms. The potential cellulose-degrading microorganisms were isolated from soil habitats. All of the 214 bacterial strains were isolated from habitats rich in cellulose. The ability of isolates to degrade cellulose was verified using the agar diffusion method, the medium I containing CNC-Na and Congo red staining (Fig. 1). The results obtained indicated that only 84 strains showed cellulolytic activity. Among these 84 strains, 34 isolates indicated strong activity (clearance zone over 20 mm). It was certainly found that there were no significant differences between supernatant and biomass isolates activity. The next step of screening of cellulose-degrading microorganisms was to observe the morphology of 34 strains by Gram staining method. Before staining, the strains were spread onto the poor medium with the addition of manganese salt (medium II) to determine the ability of strains to spore formation (Ryu et al. 2005). Our main goal was to find the spore-forming bacteria because they are useful for producing the biopreparation. The results showed that 17 from the isolates studied belong to bacilli and form spores. The six isolates, which had the highest diameter of clearing zone both for biomass and supernatant, were selected for 16 rRNA gene sequencing and identification (strain assigned as 6/5, 6/6, 4/3, 4/7, 4/11, 4/18).
The results of the identification of these strains were given in Table II. Not all isolates were clearly identified using this method. The strains 6/5 and 6/6 belong to other genera than Bacillus and for this reason they were excluded. The other strains (4/3, 4/7, 4/11, 4/18) were selected for further studies.
The results of identification of cellulose-degrading bacteria, based on the 16 rRNA gene sequencing.
| Number of strain | Identity (%) | Strain of the closest match |
|---|---|---|
| 4/3 | 86.09 | Bacillus pseudomycoides |
| 85.84 | Bacillus cereus | |
| 4/7 | 99.86 | Bacillus subtilis |
| 4/11 | 99.93 | Bacillus cereus |
| 99.86 | Bacillus thuringiensis | |
| 4/18 | 99.86 | Bacillus licheniformis |
| 6/5 | 100.00 | Achromobacter piechaudi |
| 100.00 | Alcaligenes faecalis | |
| 99.93 | Achromobacter xylosoxidans | |
| 6/6 | 99.97 | Lactococcus lactis |
The microorganisms with high cellulolytic potential have previously been isolated from various natural environments, like soil (Irfan et al. 2012; Liang et al. 2014; Hussain et al. 2017), mangrove soil (Behera et al. 2014), gut of termites (Upadhyaya et al. 2012) or grass carp (Li et al. 2016), woody organisms (caterpillar, bookworm, snail) (Gupta et al. 2012), and kitchen wastes (Kaur and Arora 2012). Cellulolytic enzymes are synthesized by aerobic and anaerobic bacteria, actinomycetes, fungi, and certain protozoa. The bacteria with such activity, belong to Clostridium, Aeromonas, Enterobacter, Actinomyces, Bacillus, Bacteroides, Butyrvibrio, Ruminococcs, Methanobrevibacter, Sedimentibacter, Comamonas, and other genera (Gupta et al. 2012; Li et al. 2016; Kanokratana et al. 2018). The strains with high cellulolytic activity isolated in our work were identified as Bacillus spp. Bacilli are a group of rod-shaped, gram-positive, aerobic or relatively anaerobic bacteria, which are able to form dormant spores (endospores) under adverse environmental conditions (Maughan and Auwera 2011). Spores may remain viable for a long time and are resistant to high and low temperatures, chemicals, sunlight and drought (Nicholson et al. 2000). These features make the bacilli nearly ideal bacteria for biopreparation.
The effect of temperature on the synthesis of cellulolytic enzymes. The ability to growth and synthesis of cellulose-degrading enzymes by the selected bacterial strains was investigated in liquid cultures (medium I, according to Gupta et al. 2012) containing CMC-Na, filter paper or milled straw as the sole source of carbon. The range of cellulose substrates was extended to tissue paper (a frequently used substrate) and straw (a target substrate), because CMC is very convenient in isolation media (soluble derivatives of cellulose), but can be degraded by microorganisms able to endoglucanase synthesis in the absence of significant activity against native cellulose (McDonald et al. 2012). Bacillus circulans 26b and Bacillus coagulans 29b from the collection of the Department of Biotechnology and Food Microbiology, with confirmed cellulolytic activity, were used for comparative purposes. The results of these investigations were shown in Fig. 2. All strains examined showed cellulolytic enzymes activity in the temperature range studied (4–42°C). All cellulose substrates as a carbon source could be utilized by these strains. The lowest cellulolytic activity was noticed at 4 and 15°C (Fig. 2). The optimal temperature of cellulolytic enzymes synthesis was in the range of 21–42°C (depending on the strain and carbon source). The highest activity was observed for isolates 4/7 (identified as Bacillus subtilis) and 4/18 (identified as Bacillus licheniformis) in temperature 32°C and these isolates were selected for further studies.

The influence of temperature on cellulolytic activity of the strains examined.
(a) 4/3; (b) 4/7; (c) 29.b; (d) 4/11; (e) 4/18; (f) 26.b. (■) CMC-Na; (•) Tissue paper; (▲) Straw.
Most complexes of cellulolytic enzymes indicate the highest activity between 50–60°C (Irfan et al. 2012; Liang et al. 2014; Wesolowska-Trojanowska and Targoński 2014). In our study, the range of temperature examined was between 4 and 42°C. It was due to the fact that we were looking for the bacteria, which could be a component of biopreparation, able to grow and cellulases synthesis during autumn in Poland when the temperatures are not so high. The results obtained indicated that some environmental strains (4/7 and 4/18) were able to effective production of cellulose-degrading enzymes in temperatures lower than 50°C (in comparison with strains 26b and 29b). Similar findings were also reported by Liang et al (2014), who indicated the good cellulases activity and thermostability at 30°C (enzymes from Paenibacillus terrae that were isolated from natural reserves in China). The optimum pH for such enzymes is 5.5–6.5 for celullases of fungal origin (Wesolowska-Trojanowska and Targoński 2014; Duta et al. 2018) and pH value up to 8 for cellulases of bacterial origin (Irfan et al. 2012). The most efficient bacterial growth of the species examined (Bacillus subtilis and Bacillus licheniformis) was found at pH 7 (data not present) and further experiments were carried out at the temperature 32°C and pH 7.
The effect of nitrogen sources on the synthesis of cellulolytic enzymes. The data collected in Table III indicated that the activity of cellulose-degrading enzymes differed significantly depending on the composition of the cultivation media. The highest enzyme activity of 91.8 U was obtained for strain 4/7 with the mixture comprising a 1:1 ratio of yeast extract and (NH4)2SO4 (run 14). When NH4Cl was used as the sole nitrogen source, the enzyme activity reached the lowest values – 16.7 U for strain 4/18 (run 4).
The response data for the cellulose-degrading enzymes activity [U] of each experimental point after the cultivation of the selected strains on the media containing various substrates for 120 h.
| Run | 4/7 – Bacillus subtilis | 4/18 – Bacillus licheniformis | ||||
|---|---|---|---|---|---|---|
| CMC-Na | Tissue paper | Straw | CMC-Na | Tissue paper | Straw | |
| 1 | 73.341 | 69.931 | 76.155 | 84.545 | 45.651 | 54.975 |
| 2 | 51.870 | 46.036 | 57.331 | 47.838 | 48.956 | 18.901 |
| 3 | 78.858 | 81.562 | 70.540 | 86.859 | 43.448 | 33.492 |
| 4 | 44.842 | 37.608 | 38.008 | 49.592 | 16.792 | 20.351 |
| 5 | 86.250 | 69.578 | 90.502 | 67.032 | 47.400 | 25.125 |
| 6 | 67.130 | 59.652 | 22.006 | 70.089 | 42.723 | 51.931 |
| 7 | 63.610 | 61.600 | 55.361 | 59.664 | 45.89 | 21.751 |
| 8 | 75.801 | 61.600 | 31.052 | 72.537 | 46.864 | 31.312 |
| 9 | 65.790 | 70.978 | 64.362 | 52.856 | 35.44 | 30.849 |
| 10 | 64.633 | 45.841 | 18.583 | 47.315 | 40.568 | 21.191 |
| 11 | 67.991 | 46.718 | 48.692 | 40.523 | 69.297 | 25.819 |
| 12 | 81.805 | 74.096 | 67.183 | 41.298 | 50.323 | 21.398 |
| 13 | 58.227 | 64.584 | 67.386 | 17.805 | 33.017 | 41.822 |
| 14 | 91.841 | 46.815 | 55.102 | 22.799 | 38.85 | 20.497 |
| 15 | 66.825 | 71.173 | 41.523 | 32.724 | 42.395 | 23.676 |
| 16 | 67.451 | 30.849 | 48.943 | 40.674 | 58.946 | 20.022 |
| 17 | 66.886 | 66.850 | 74.287 | 80.405 | 45.374 | 56.023 |
| 18 | 48.983 | 41.919 | 54.057 | 43.417 | 48.097 | 19.754 |
| 19 | 72.537 | 76.958 | 68.496 | 78.736 | 43.021 | 34.637 |
| 20 | 42.529 | 32.785 | 35.983 | 43.71 | 16.822 | 20.972 |
To estimate the true influence of the cultivation medium composition on the enzyme activity, the collected data was analyzed with the use of backward stepwise regression. Reduced special cubic × main effects model was adequately fitted to the response of enzyme activity for both strains. Regression models for strain 4/7 and 4/18 accounted for about 89 and 94% of variations, respectively (Table IV).
Regression coefficients and the selected fit statistics for two strains investigated.
| Component in model | 4/7 – Bacillus subtilis | 4/18 – Bacillus licheniformis | ||||
|---|---|---|---|---|---|---|
| CMC-Na | Tissue paper | Straw | CMC-Na | Tissue paper | Straw | |
| A | 14.010 | 13.758 | 15.113 | 16.453 | 9.146 | 11.111 |
| B | 9.885 | 8.696 | 11.233 | 9.128 | 9.797 | 3.789 |
| C | 15.096 | 15.718 | 13.633 | 16.565 | 8.661 | 6.956 |
| D | 8.724 | 7.120 | 7.468 | 9.490 | 3.248 | 4.099 |
| A×B | 3.277 | 3.000 | 0.597 | −3.483 | 0.494 | −2.712 |
| A×C | −0.808 | −5.549 | −3.786 | −6.638 | 3.085 | −3.472 |
| A×D | 1.294 | −0.602 | −5.714 | −2.414 | 1.225 | −2.800 |
| B×C | 4.399 | −2.491 | −1.287 | −6.412 | −1.193 | −0.983 |
| B×D | 1.619 | 4.134 | 3.687 | −4.134 | −0.166 | 3.289 |
| C×D | 1.161 | 2.324 | −1.994 | −4.717 | 1.665 | −0.530 |
| A×B×C | −5.876 | −4.340 | −31.119 | 18.744 | −8.735 | −6.175 |
| B×C×D | 5.785 | 9.842 | 24.012 | 8.648 | 8.648 | 8.648 |
| Adj-R2 | 0.886 | 0.941 | ||||
| Model p-value | < 0.0001 | < 0.0001 | ||||
A: Casein peptone; B: (NH4)2SO4; C: Yeast extract; D: NH4Cl
According to the results obtained, the concentration of casein peptone and yeast extract has the most significant impact on enzyme activity. For instance, yeast extract had the lowest p-value (> 0.0001) and the highest positive beta value (16.565), indicating that an increase in the concentration of this compound will increase enzyme production (Table IV). The same pattern was found with a casein peptone, which is confirmed by the literature data, e.g. Ray et al. (2007). On the other hand, in the concentration range tested in this experimental design, NH4Cl was found to have a weak influence on enzyme production. As demonstrated in this study, with a growth-limiting concentration of organic nitrogen source, the Bacillus strains produced lower levels of cellulose-degrading enzymes when compared to a medium with a sufficient nitrogen source concentration. Probably, some organic and inorganic compounds present in the yeast extract and casein peptone could induce the extracellular enzyme production. Glutamine is one of the most important compounds because it provides the link between carbon and nitrogen metabolism in living cells. It has been reported by Manabe et al. (2011) that glutamate metabolism influences the synthesis of secreted proteins. Toya et al. (2014) added it to the medium and found that the cellulase production by Bacillus subtilis increased approximately 10 times. Furthermore, 80–88% of the nitrogen that is incorporated into biomass is delivered by glutamate (Gunka and Commichau 2012). As glutamate is part of any naturally occurring protein, it is also present in yeast extract, a complex hydrolysate of yeasts, rich in nitrogenous compounds, carbon, trace nutrients and vitamin B. Glutamate content accounts for approximately 8% or more of a total mass of yeast extract (Podpora et al. 2016). This might be an explanation for the predominant role of yeast extract in the synthesis of bacterial cellulases by both Bacillus strains investigated.
On the other hand, for both strains, the CMC-Na brought the highest cellulases production compared to other carbon sources at 120 h incubation (Fig. 3). A soluble CMC-Na molecule provides a distinct advantage over the other materials used. Fibrous material such as mentioned above tissue paper and straw have a tendency to absorb some quantities of water and thus lead to highly viscous media. The limitations of using tissue paper and straw for cellulases production are related also to the nutrient availability. According to Wood and Bhat (1988), CMC-Na is less complex structure and therefore, the bacteria can more easily assimilate it. Due to these considerations, CMC-Na seems desirable carbon source for the strains investigated. The effect of various carbon sources (glucose, xylose, carboxymethyl cellulose) on the production of cellulases by the fungus Phlebia gigantean has been conducted, with CMC proving the best results (Niranjane et al. 2007).

Comparison of the activity of cellulose-degrading enzymes from B. subtilis (2a) and B. licheniformis (2b). An initial casein peptone, (NH4)2SO4, yeast extract and NH4Cl concentrations were 1.25 g/l.
To estimate the optimum composition of the cultivation media regarding nitrogen source, the optimization calculations were conducted using the simplex method, which provides excellent results in the search for the local maximums of functions of several variables (Bialas et al. 2016). It is worth to point out that a common problem in the industrial microbial processes is to find a set of conditions for the input variables (e.g. concentration of raw materials) that ensures the highest enzyme activity and low manufacturing cost as well. The standard growth media employed to cultivate Bacillus strains, containing yeast and beef extract, are expensive for industrial applications. The yeast extract cost is about 5.95 euro/kg, which is two times higher than the current price of the casein peptone. Thus, with regard to cost economics, casein peptone should be more efficient than yeast extract. Therefore, the following conditions were imposed during optimization: the casein peptone, (NH4)2SO4 and NH4Cl had the goal limits in the range tested in design space. At the same time, the yeast extract was maintained at the lowest possible level, as it was the most expensive component of the medium. Since the standard error of dependent variable plays an important role in the assessment of prediction quality, optimization of the overall desirability function involved also minimization of this statistical parameter.
Applying desirability function methodology, the optimal medium compositions to achieve a simple, cost-efficient cellulases production process were developed for both strains. According to these calculations, the medium should contain only casein peptone, (NH4)2SO4 and yeast extract in its composition (Fig. 4). There is no need to use the fourth of the studied compound, NH4Cl. The predicted cellulosic enzyme activity should be equal to 75.1 ± 2.87 U and 75.1 ± 2.28 U, for a strain 4/7 and 4/18, respectively.

Contour plot depicting the relation between casein peptone, (NH4)2SO4 and yeast extract and the cellulolytic activity of both strains, Bacillus subtilis (a) and Bacillus licheniformis (b).
New microbial species producing higher concentrations of cellulases should be searched to develop economically competitive biostrategies, like biopreparation. Natural environment may be a rich source of microorganisms with unique properties. We isolated from habitats rich in cellulose bacteria belonging to Bacillus spp., which were further identified as Bacillus subtilis (4/7) and Bacillus licheniformis (4/18). These bacteria strains, living in niches rich in cellulose, developed the ability to effectively synthesize cellulose-degrading enzymes in environmental conditions. Organic nitrogen sources were found to be more suitable for optimizing cellulase production by Bacillus subtilis and Bacillus licheniformis than inorganic sources.